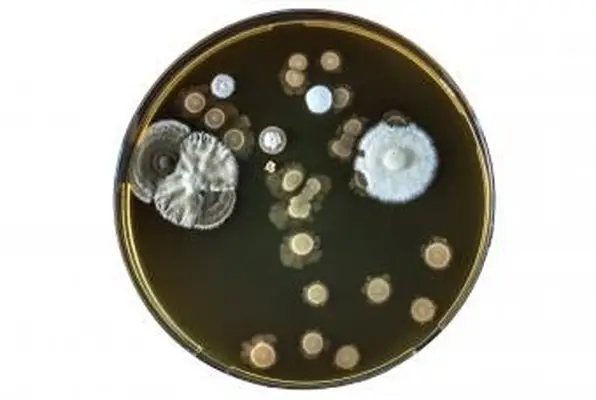
szalka Petriego z blastomyces dermatitidis

Chociaż wiele rodzajów kaszlu nie jest bezpośrednio niebezpiecznych dla zdrowia Twojego psa, każdy pies, który podczas kaszlu trzyma głowę i szyję w nietypowy sposób lub ma problemy z oddychaniem, powinien natychmiast zgłosić się do weterynarza. Kaszel u psa może wskazywać na kilka rodzajów problemów. Niektóre z nich mogą być samoograniczającymi się lub niewielkimi problemami, podczas gdy inne mogą być przewlekłymi lub zagrażającymi życiu schorzeniami.
Rodzaje dźwięków kaszlu
Kiedy pies kaszle, może to brzmieć przerażająco. Trudno jest zidentyfikować przyczynę kaszlu na podstawie tego, jak brzmi, ale wiedza, czego należy słuchać, może pomóc w ustaleniu, co robić dalej. Strona dla zwierząt pet vetStreet identyfikuje kilka różnych rodzajów dźwięków, które możesz usłyszeć, gdy twój pies kaszle:
- Problemy zdrowotne psa
- Rozpoznawanie objawów robaczycy serca u psów
- Zaopatrzenie potomstwa
- Suchy kaszel, który można wywołać palpacją gardła
- Krztuszenie się lub odruchy wymiotne
- Wydzielina z nosa
- Utrata apetytu
- Letarg lub apatia
- Gorączka
- Mokry kaszel
- Zwiększona częstość oddechów
- Trudne oddychanie
- Gruba wydzielina z nosa
- Gorączka
- Letarg lub apatia
- Utrata apetytu
- Gęsi kaszel
- Trudne oddychanie
- Nietolerancja ćwiczeń in
- Epizody omdlenia
- Niebieski wygląd języka i dziąseł
- Unikaj używania smyczy na szyję i załóż uprząż.
- Postaraj się zminimalizować podekscytowanie.
- Unikaj silnych oparów z dymu papierosowego lub środków czyszczących.
- Suchy kaszel lub mokry kaszel
- Nietolerancja ćwiczeń in
- Kaszel po pierwszym przebudzeniu
- Trudne oddychanie
- świszczący oddech
- Kaszel z podniecenia
-
Nietolerancja ćwiczeń
-
Szybkie oddychanie
-
Trudności w oddychaniu
-
Mokry kaszel
-
Półomdlały
- Kaszel
- Nagłe sapanie i niewydolność oddechowa
- Zawalić się
- Niebieskie dziąsła i język
- Gorączka
- Letarg lub apatia
- Utrata apetytu
- Kaszel, zwykle przewlekły
- Trudne oddychanie
- Letarg lub apatia
- Utrata apetytu
- Utrata masy ciała
- Odkrztuszanie flegmy lub krwi
- Kuśtykający
- Kaszel
- Zwiększona częstość oddechów
- Niewydolność oddechowa
- Niebieskie dziąsła lub język
- Gorączka
- Letarg lub apatia
- Utrata apetytu
- Nietolerancja ćwiczeń in
- Powiększone węzły chłonne
- Zmiany oczu
- Opróżnianie ran na skórze
- Kuśtykający
- Duszność
- Suchy kaszel
- Letarg
- Utrata masy ciała
- Nietolerancja ćwiczeń in
- Zastoinowa niewydolność serca
- Mokry kaszel
- Utrata apetytu
- Gorączka
- Wydzielina z nosa
- Letarg lub apatia
- Zwiększona częstość oddechów
- Zapalenie płuc
- Zapalenie spojówek
- Trudne oddychanie
- Wymioty
- Biegunka
- Utrata masy ciała
- Zmiany oczu
- Objawy neurologiczne
- Wysypka skórna
Jednak dla wielu kaszlących psów rasa i wiek psa mogą być ważniejsze w kategoryzowaniu możliwych przyczyn niż dźwięk kaszlu.
Hodowla kaszlu
Ta przyczyna kaszlu jest bardzo powszechną chorobą zakaźną u psów, podobną do przeziębienia u ludzi. Kaszel hodowlany może być spowodowany przez bakterie Bordetella bronchiseptica lub niektóre wirusy.
Typowe objawy kaszlu hodowlanego to:
Łagodne przypadki kaszlu hodowlanego mogą nie wymagać leczenia. W tych, które to robią, twój weterynarz prawdopodobnie przepisze antybiotyki i środek przeciwkaszlowy.
Jak brzmi hodowla kaszlu?
Kaszel hodowlany może być bardzo niepokojącym dźwiękiem, szczególnie dla nowych właścicieli psów. Odgłosy kaszlu brzmią bardzo podobnie do tego, że twój pies krztusi się i krztusi. Jeśli kiedykolwiek słyszałeś, jak kot przechodzi obok kuli włosowej, to podobny hałas to brzmi, jakby to było produktywne (tj. żółć, wymioty), a nie suchy kaszel.
Zapalenie płuc
U psów mogą wystąpić dwa główne rodzaje zapalenia płuc (infekcja płuc): zakaźne zapalenie płuc i zachłystowe zapalenie płuc.
Rodzaje zapalenia płuc
W zakaźne zapalenie płuc , bakterie przemieszczają się z gardła do płuc. Zakaźne zapalenie płuc jest szczególnie powszechne u szczeniąt, u których pierwszy kaszel hodowlany jest wtórny do Bordetella. jednak , zapalenie płuc może również wystąpić jako wtórne powikłanie infekcji wirusowej lub innych bakterii. Psy geriatryczne lub te z innymi schorzeniami, takimi jak cukrzyca lub choroba Cushinga, mogą również być narażone na zwiększone ryzyko zachorowania na zapalenie płuc.

Aspiracyjne zapalenie płuc występuje, gdy pies wymiotuje lub zwraca, ale drogi oddechowe nie zamykają się, aby zapobiec przedostawaniu się płynu do tchawicy i płuc. Stany predysponujące zwierzę do aspiracji obejmują porażenie krtani, przełyk lub znieczulenie. Aspiracja tego płynu powoduje chemiczne uszkodzenie płuc, co prowadzi do stanu zapalnego, a później infekcji bakteryjnej.
Objawy zapalenia płuc
Objawy każdego rodzaju zapalenia płuc mogą obejmować:
Diagnoza zapalenia płuc
Twój weterynarz może zdiagnozować zapalenie płuc za pomocą połączenia badania fizykalnego (słuchanie płuc) i prześwietlenia klatki piersiowej. Badania krwi mogą być pomocne w znalezieniu innych czynników, które mogą przyczynić się do przyczyn leżących u podstaw. Czasami twój weterynarz może zlecić specjalny test, aby pobrać próbkę z płuc, aby określić, jaki rodzaj bakterii powoduje infekcję i który antybiotyk będzie działał najlepiej. W przypadku psów z aspiracyjnym zapaleniem płuc weterynarz może potrzebować dodatkowych testów, aby zdiagnozować przyczynę aspiracji.
Leczenie zapalenia płuc
Leczenie zapalenia płuc u psów będzie się różnić w zależności od ciężkości choroby. W łagodnym przypadku, w którym pies nadal je i nie ma trudności z oddychaniem, lekarz weterynarii może przepisać antybiotyki i ewentualnie lek rozszerzający oskrzela. Twój weterynarz zazwyczaj unika przepisywania leków przeciwkaszlowych, ponieważ kaszel może być pomocny w usuwaniu wydzieliny z dróg oddechowych.
W cięższym przypadku zapalenia płuc, w którym pies nie je, ma wysoką gorączkę lub trudności w oddychaniu, często wymagana jest hospitalizacja. Lekarz weterynarii może podawać tlen w specjalnej komorze, płyny dożylne i antybiotyki oraz lek rozszerzający oskrzela. Pomocna może być również nebulizacja solą fizjologiczną lub antybiotykiem.
Terapia oddechowa może również pomóc Twojemu psu wyzdrowieć z zapalenia płuc. Ten rodzaj terapii jest zwykle nazywany kupażem, a leczenie pomaga rozluźnić wydzieliny w płucach, aby Twój zwierzak mógł je wykasływać. Kupaż jest często wykonywany u pacjentów hospitalizowanych; jednak można to również zrobić w domu.
Większość psów z zapaleniem płuc wraca do zdrowia po leczeniu. Twój pies może potrzebować antybiotyków przez kilka tygodni, a prześwietlenie klatki piersiowej może pomóc w ustaleniu, czy infekcja została wyleczona.
Zapadnięcie tchawicy
Według American College of Veterinary Surgeons , zapaść tchawicy występuje najczęściej u psów małych ras w średnim lub starszym wieku. Tchawica lub tchawica składa się z kilku pierścieni chrząstki w kształcie litery C. U niektórych psów chrząstka słabnie i zaczyna się spłaszczać, zwężając drogi oddechowe. Może to prowadzić do zapalenia dróg oddechowych i kaszlu.
Objawy zapadnięcia tchawicy
Objawy zapadnięcia tchawicy obejmują:
Objawy zapadnięcia tchawicy często nasilają się pod wpływem podniecenia lub ćwiczeń.
Diagnoza zapadnięcia tchawicy
Twój weterynarz będzie podejrzewał zapaść tchawicy, jeśli twój pies jest małej rasy i ma klasyczny kaszel gęsi. W większości przypadków diagnoza może zostać potwierdzona przez lekarza weterynarii, wykonując prześwietlenie szyi i klatki piersiowej. W przypadku niektórych psów mogą być potrzebne inne testy, takie jak fluoroskopia lub endoskopia.
Leczenie zapadnięcia tchawicy
Leczenie zapadnięcia tchawicy zwykle wymaga leczenia od weterynarza. Pomocne mogą być leki uspokajające, przeciwzapalne i rozszerzające oskrzela. Jeśli twój pies ma przewlekłą chorobę dróg oddechowych, weterynarz może również przepisać antybiotyki. W ciężkich przypadkach pies może wymagać hospitalizacji w celu uzyskania tlenu i monitorowania. Psy z ciężkim nawracającym zapaścią tchawicy mogą wymagać operacji, aby mieć dobrą jakość życia. W tradycyjnej chirurgii plastikowe pierścienie są wszczepiane w szyję, aby wspomóc tchawicę. Nowsza technika polega na umieszczeniu rozszerzalnego stentu przez usta i tchawicę.
Możesz zmniejszyć ryzyko przyszłych epizodów zapadnięcia się tchawicy, upewniając się, że zwierzę ma zdrową wagę. Możesz także:
Przewlekłe zapalenie oskrzeli
Psy z przewlekłym zapaleniem oskrzeli rozwijają kaszel przez co najmniej dwa miesiące. Ten stan występuje, gdy dolne drogi oddechowe (oskrzela) ulegają podrażnieniu i rozwijają się ciągłe stany zapalne. Najczęściej występuje u starszych psów, małych ras i psów otyłych. Przewlekłe zapalenie oskrzeli jest nieodwracalnym stanem długotrwałym.
Objawy przewlekłego zapalenia oskrzeli
Objawy przewlekłego zapalenia oskrzeli obejmują:
Diagnoza przewlekłego zapalenia oskrzeli
Twój lekarz weterynarii wstępnie zdiagnozuje przewlekłe zapalenie oskrzeli słuchając płuc psa i robiąc zdjęcia rentgenowskie klatki piersiowej. Te wstępne testy pomogą wykluczyć inne rodzaje chorób płuc, ale konkretna diagnoza przewlekłego zapalenia oskrzeli wymaga płukania oskrzelowo-pęcherzykowego w celu pobrania próbki z płuc psa. Laboratorium oceni następnie próbkę pod mikroskopem, aby określić, jakie typy komórek są obecne, aby postawić diagnozę.
Leczenie i postępowanie w przewlekłym zapaleniu oskrzeli
Leczenie przewlekłego zapalenia oskrzeli może obejmować różne leki, w tym doustne kortykosteroidy, lek rozszerzający oskrzela, środek przeciwkaszlowy lub kortykosteroidy podawane za pomocą inhalatora i specjalny adapter . W niektórych przypadkach krótki cykl antybiotyków może złagodzić objawy. Poważne przypadki przewlekłego zapalenia oskrzeli mogą wymagać hospitalizacji w celu tlenoterapii, wziewnych leków rozszerzających oskrzela lub szybko działających kortykosteroidów.
Utrata masy ciała jest ważna, aby pomóc w radzeniu sobie z przewlekłym zapaleniem oskrzeli psa. Przydatna może być również zmiana ze smyczy na szyję na uprząż i unikanie czynników drażniących, takich jak dym papierosowy lub produkty o silnym zapachu. Bakterie w jamie ustnej z powodu choroby zębów mogą prowadzić do powikłań, więc jeśli Twój pies ma poważny kamień nazębny i chorobę przyzębia, powinien to zrobić weterynarz.
Zastoinowa niewydolność serca
Jedną z najpoważniejszych przyczyn kaszlu u psów jestzastoinowa niewydolność serca. Dzieje się tak, gdy serce nie może skutecznie pompować z powodu nieszczelnej zastawki, powiększenia serca lub chorób mięśni serca. W niektórych rodzajach niewydolności serca w płucach gromadzi się płyn, co prowadzi do zaburzeń oddechowych i kaszlu.
Objawy zastoinowej niewydolności serca
Objawy zastoinowej niewydolności serca obejmują:
Diagnostyka i leczenie zastoinowej niewydolności serca
Jeśli uważasz, że Twój pies może mieć zastoinową niewydolność serca, potrzebna jest natychmiastowa wizyta u weterynarza. Niektóre zwierzęta z ciężką niewydolnością oddechową będą wymagały tlenu i leków, zanim będą mogły zostać wykonane jakiekolwiek testy. Lekarz weterynarii może postawić wstępną diagnozę niewydolności serca na podstawie objawów, wieku i rasy psa oraz nasłuchując w płucach dźwięków związanych z gromadzeniem się płynów lub szmerem serca. Rozpoznanie zastoinowej niewydolności serca można zwykle postawić na podstawie badania fizykalnego i prześwietlenia klatki piersiowej. W przypadku niektórych psów może być konieczne wykonanie echokardiogramu (USG serca), ale w wielu przypadkach nie można tego wykonać natychmiast.
Większość psów z zastoinową niewydolnością serca będzie wymagać hospitalizacji, przynajmniej przez kilka godzin, ale prawdopodobnie kilka dni. Twój pies zazwyczaj otrzymuje tlen, lek moczopędny, inhibitor enzymu konwertującego angiotensynę (enalapryl lub benazepril) oraz pimobendan, który wspomaga pracę serca.
Ciało obce
Niezwykłą przyczyną kaszlu u psów jest ciało obce w drogach oddechowych lub płucach. Może się to zdarzyć nagle i spowodować natychmiastową zagrażającą życiu niedrożność dróg oddechowych, w wyniku której pies się dusi. W innych przypadkach mniejszy kawałek obcego materiału, taki jak skała, trawa trawnik lub nasiona trawy mogą przedostać się do organizmu i utknąć w tchawicy lub płucach.
Objawy ciała obcego w drogach oddechowych
Objawy ciała obcego w drogach oddechowych obejmują:
Diagnoza i leczenie nagłego zadławienia
Istnieje kilka sposobów diagnozowania ciała obcego w drogach oddechowych. Jeżeli twójzwierzak aktywnie się dusi, możesz spróbować wykonać zmodyfikowany manewr Heimlicha, zanim jak najszybciej udasz się do gabinetu weterynarza. Weterynarz może zdiagnozować nagłą niedrożność dróg oddechowych na podstawie charakterystyki oddychania psa. Konieczna jest natychmiastowa tlenoterapia, sedacja i wydobycie obiektu. Jeśli obiektu nie można szybko usunąć, psa może być potrzebna intubacja w celu ułatwienia oddychania lub wykonanie tracheostomii w celu utworzenia alternatywnej drogi oddechowej w szyi.
Diagnoza i leczenie przewlekłego ciała obcego
W przypadku bardziej przewlekłego ciała obcego weterynarz może czasami postawić diagnozę za pomocą prześwietlenia szyi i klatki piersiowej. W niektórych przypadkach weterynarz może chcieć wykonać tomografię komputerową, fluoroskopię lub bronchoskopię.
Leczenie przewlekłego ciała obcego będzie zależeć od dokładnej lokalizacji obiektu. Czasami weterynarz może pobrać ciało obce za pomocą bronchoskopii. Podczas bronchoskopii zwierzę umieszcza się w znieczuleniu, a przez tchawicę wprowadza się małą lunetę światłowodową do poziomu niedrożności. Do uchwycenia przedmiotu i odzyskania go używa się maleńkich instrumentów. Jeśli obiekt nie jest dostępny za pomocą bronchoskopii, może być konieczna operacja.
Rak
Niestety rak występuje powszechnie u psów wraz z wiekiem. Ze wszystkich rodzajów raka guzy płuc są rzadkie, ale częściej rozwijają się u psów dużych ras. Psy brachycefaliczne (rasy krótkonose) mają zwiększone ryzyko raka płuc, gdy są narażone na bierny dym papierosowy. Rak płuc może występować jako guz pierwotny lub jako choroba przerzutowa, która rozpoczyna się w innym miejscu organizmu i rozprzestrzenia się do płuc w późnych stadiach choroby.
Objawy raka płuc
Według Caninecancer.com , objawy raka płuc u psów obejmują:
Opcje diagnozy i leczenia raka płuc
Rak płuc może naśladować wiele innych chorób, które powodują kaszel u psów. Twój weterynarz może zwykle postawić wstępną diagnozę za pomocą prześwietlenia klatki piersiowej, ale potwierdzenie może wymagać wielu dodatkowych testów lub biopsji.
Leczenie pierwotnego guza płuca prawdopodobnie będzie wymagało operacji. Jeśli operacja klatki piersiowej nie jest czymś, co może wytrzymać starszy pies, Twój weterynarz może próbować zapewnić mu komfort za pomocą kortykosteroidów, leków przeciwbólowych lub środków pobudzających apetyt. Choroba z przerzutami do płuc jest zaawansowaną formą raka, a leczenie często kończy się niepowodzeniem. Diagnoza guza głównego może być konieczna, aby jak najlepiej ukierunkować leczenie. Niektóre rodzaje raka płuc można leczyć chemioterapią lub radioterapią.
Infekcje grzybowe
Infekcje grzybicze mogą powodować kaszel u psów, szczególnie jedną z postaci wywołanych przez Blastomyces dermatitidis . Organizm ten rośnie w wilgotnej, piaszczystej, kwaśnej glebie bogatej w materię organiczną. Występuje w pobliżu wody, w dolinach Mississippi, Ohio, Missouri, Tennessee i St. Lawrence River. Czasami grzyby można znaleźć również w regionie środkowoatlantyckim, częściach Kanady i wzdłuż południowych Wielkich Jezior. Blastomykoza najczęściej występuje u młodych samców psów.
Blastomyces Dermatitidis
Objawy blastomykozy płucnej
Blastomykoza często atakuje płuca, ale inne narządy są również podatne na infekcje. Objawy mogą obejmować:
Diagnostyka i leczenie blastomykozy
Twój weterynarz może zdiagnozować blastomykozę na jeden z kilku sposobów. Jeśli uda mu się uzyskać próbkę z zainfekowanych węzłów chłonnych, płuc lub skóry, laboratorium może ocenić próbkę pod mikroskopem w poszukiwaniu organizmu. Rentgenowskie klatki piersiowej często wykazują charakterystyczny wzór zmian w płucach, ale to nie potwierdza infekcji grzybiczej. Można również wykonać badania krwi, ale należy je interpretować razem z innymi badaniami.
Leczenie blastomykozy zazwyczaj wymaga doustnych leków przeciwgrzybiczych przez długi czas. Do monitorowania, czy choroba została wyleczona, czy nie, można zastosować specjalny test moczu. W przypadku poważnie chorych zwierząt konieczna może być hospitalizacja z powodu płynów dożylnych i silniejszych leków przeciwgrzybiczych.
Choroba heartworm
Wiele psów przyjmuje comiesięczne leki, aby temu zapobiecinfekcja heartworm. Ta poważna choroba pasożytnicza jest przenoszona przez komary i może ostatecznie powodować kaszel u psów. Robaczyca serca występuje częściej w stanach wybrzeża Zatoki Perskiej, południowym wybrzeżu Atlantyku i dolinie rzeki Missisipi; jednak odnotowano to w Stanach Zjednoczonych, a nawet w Kanadzie.
Objawy choroby robaczycy serca u psów
Objawy robaczycy serca u psów obejmują:
Twój weterynarz może zdiagnozować robaczycę serca za pomocą badania krwi. Leczenie polega na połączeniu leków doustnych i zastrzyków podawanych w szpitalu.
Inne infekcje wirusowe
Psy są podatne na inne infekcje wirusowe, które atakują płuca. Mogą to byćpsia grypalubpsia nosówka. Choroby te są wysoce zaraźliwe, ale w większości można im zapobiegać za pomocą szczepień.
Objawy infekcji wirusowych
Objawy zarówno grypy psów, jak i nosówki mogą obejmować:
Dodatkowe objawy psiej nosówki
W przypadku nosówki u psów ciężkie przypadki mogą również wykazywać:
Diagnostyka i leczenie infekcji wirusowych
Ogólnie rzecz biorąc, weterynarz użyje testów laboratoryjnych do zdiagnozowania infekcji wirusowej. Próbki można pobrać z tylnej części gardła, spojówki oka, krwi, a nawet moczu. Leczenie tych infekcji polega na radzeniu sobie z objawami, aby Twoje zwierzę było bardziej komfortowe. Leczenie będzie się różnić w zależności od ciężkości infekcji. Weterynarze często stosują antybiotyki w celu zapobiegania lub leczenia wtórnych infekcji bakteryjnych.
Pokonaj ten kaszel
Jeśli twój pies kaszle, ważne jest, aby poszukać innych objawów i zabrać go do weterynarza, zwłaszcza jeśli kaszel utrzymuje się przez kilka dni lub towarzyszy mu ciężki oddech. Przy odrobinie uwagi, kilku testach i prawdopodobnie lekach, twój psi towarzysz szybko się wyleczy.
Wybór Redakcji
Husqvarna Hicut 64 Przegląd kosiarki
Dahlia „Ian Hislop”
Korzyści z treningu oporowego dla osób starszych
Gdzie mogę znaleźć klapki ślubne?